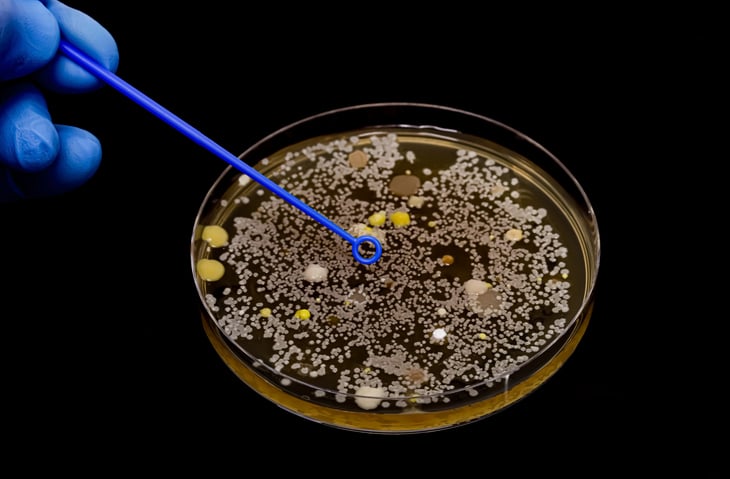

La composizione del microbioma intestinale può influenzare il rischio di sviluppare un tumore. Come? Attraverso la differente capacità di metabolizzare alcune sostanze con cui viene a contatto. Ad affermarlo è uno studio pubblicato sulla rivista Nature. Un risultato importante che potrebbe un giorno cambiare la prevenzione di alcuni tumori. Il rischio cancro indotto da sostanze inquinanti potrebbe infatti cambiare a seconda dei batteri intestinali presenti.
IL METABOLISMO DEGLI INQUINANTI
Gli inquinanti ambientali -così come molte delle molecole che introduciamo dall'esterno- quando entrano nel nostro corpo subiscono un processo di trasformazione. E' quello che in gergo tecnico gli addetti ai lavori chiamano "metabolismo". Questo processo può alterarne il potenziale cancerogeno e la distribuzione nei tessuti di un determinato inquinante. Tra i vari attori di questo processo, oltre al fegato, ci sono i microrganismi del tratto digerente. Questi possono infatti modificare chimicamente una vasta gamma di sostanze influenzando il profilo dei metaboliti risultanti e la loro esposizione ai tessuti. Tuttavia l'effetto della biotrasformazione microbica sullo sviluppo dei tumori indotto da agenti chimici è ancora in fase di studio.
LO STUDIO
Lo studio da poco pubblicato su Nature ha contribuito ad aggiungere un tassello di conoscenza sul ruolo del microbiota intestinale nel processo di sviluppo tumorale. Nell'analisi i ricercatori dell'European Molecular Biology Laboratory (EMBL) di Heidelberg hanno analizzato l'effetto del microbioma sul metabolismo delle nitrosammine, particolari sostanze potenzialmente cancerogene presenti in alcuni alimenti. Dalle analisi, effettuate in modello animale, è emerso che in assenza di microbioma il rischio di tumore della vescica (una neoplasia associata all'esposizione cronica a queste sostanze) si riduceva drasticamente. Un risultato che mostra chiaramente il ruolo del metabolismo dei batteri nell'influenzare l'effetto di determinate inquinanti.
LA RISPOSTA VARIA A SECONDA DEL MICROBIOMA
Ma c'è di più. Andando a valutare in laboratorio l'effetto delle nitrosammine su differenti popolazioni batteriche prelevate da donatori, è emerso che il metabolismo dei carcinogeni da parte del microbioma varia da persona a persona. Un risultato che suggerisce come il microbioma possa influenzare significativamente il rischio individuale di tumore indotto da agenti inquinanti. Tradotto: la stessa sostanza potrebbe avere effetti differenti a seconda della composizione del microbioma.